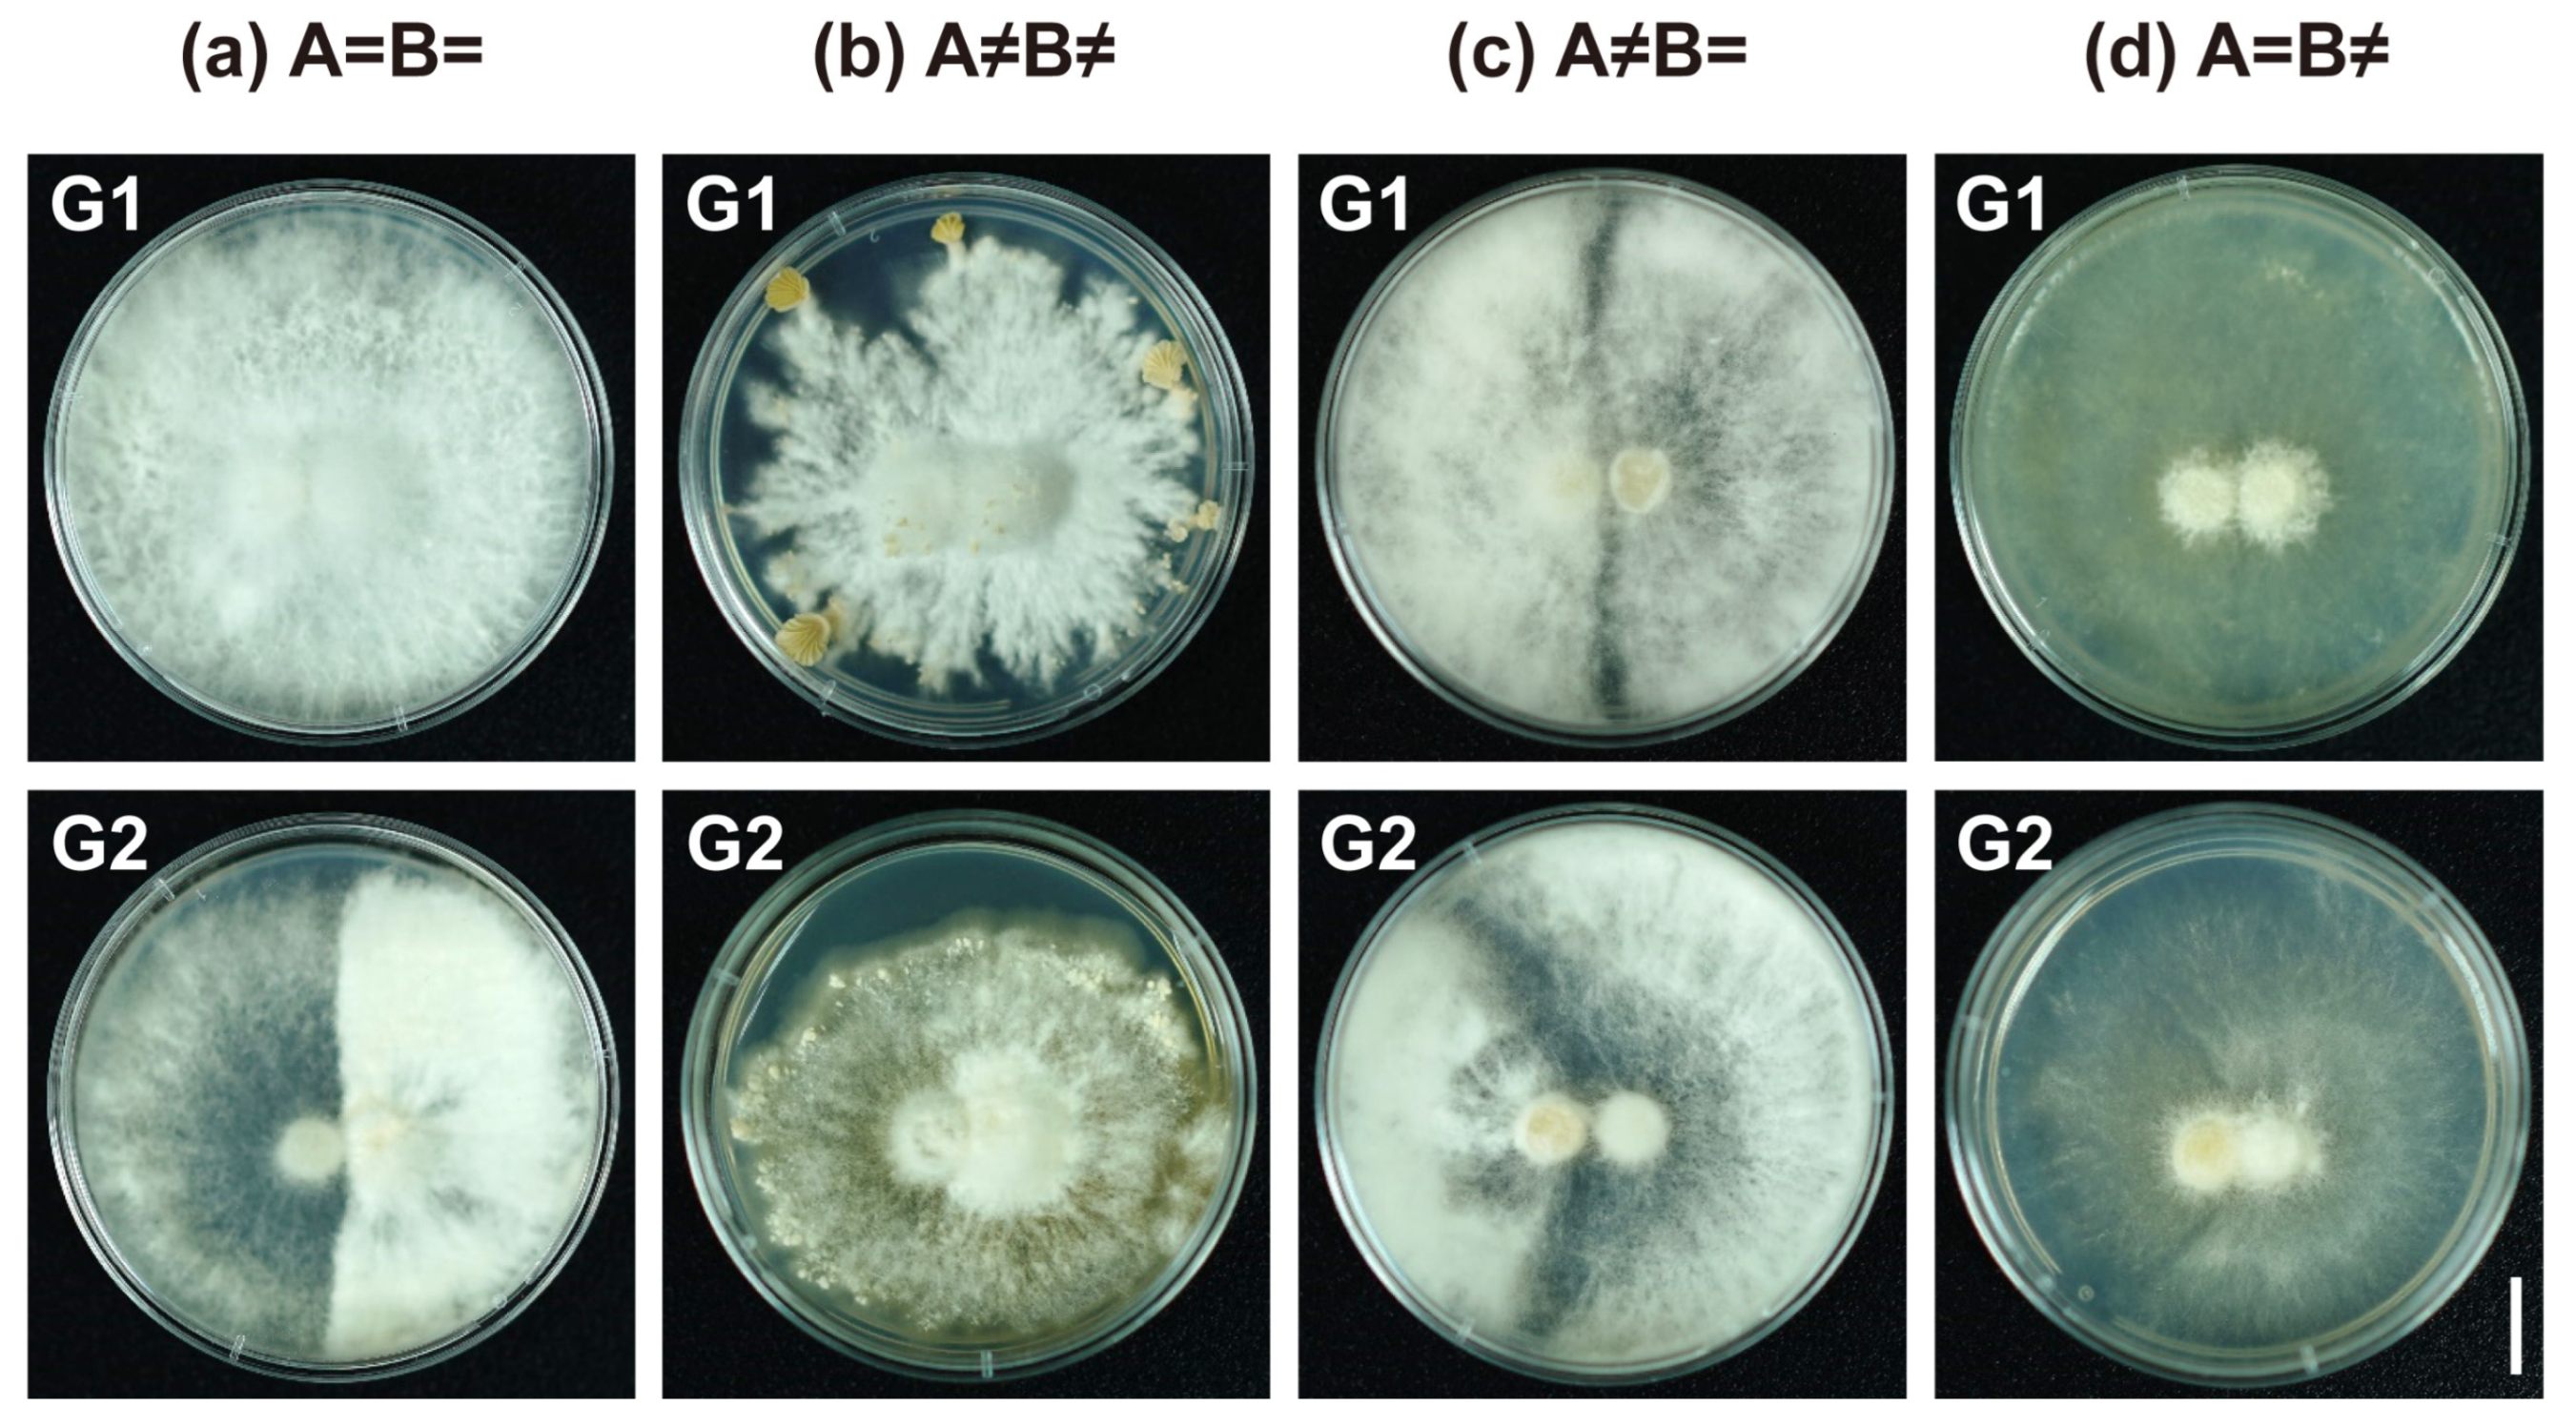
Jof 11 00277 g002
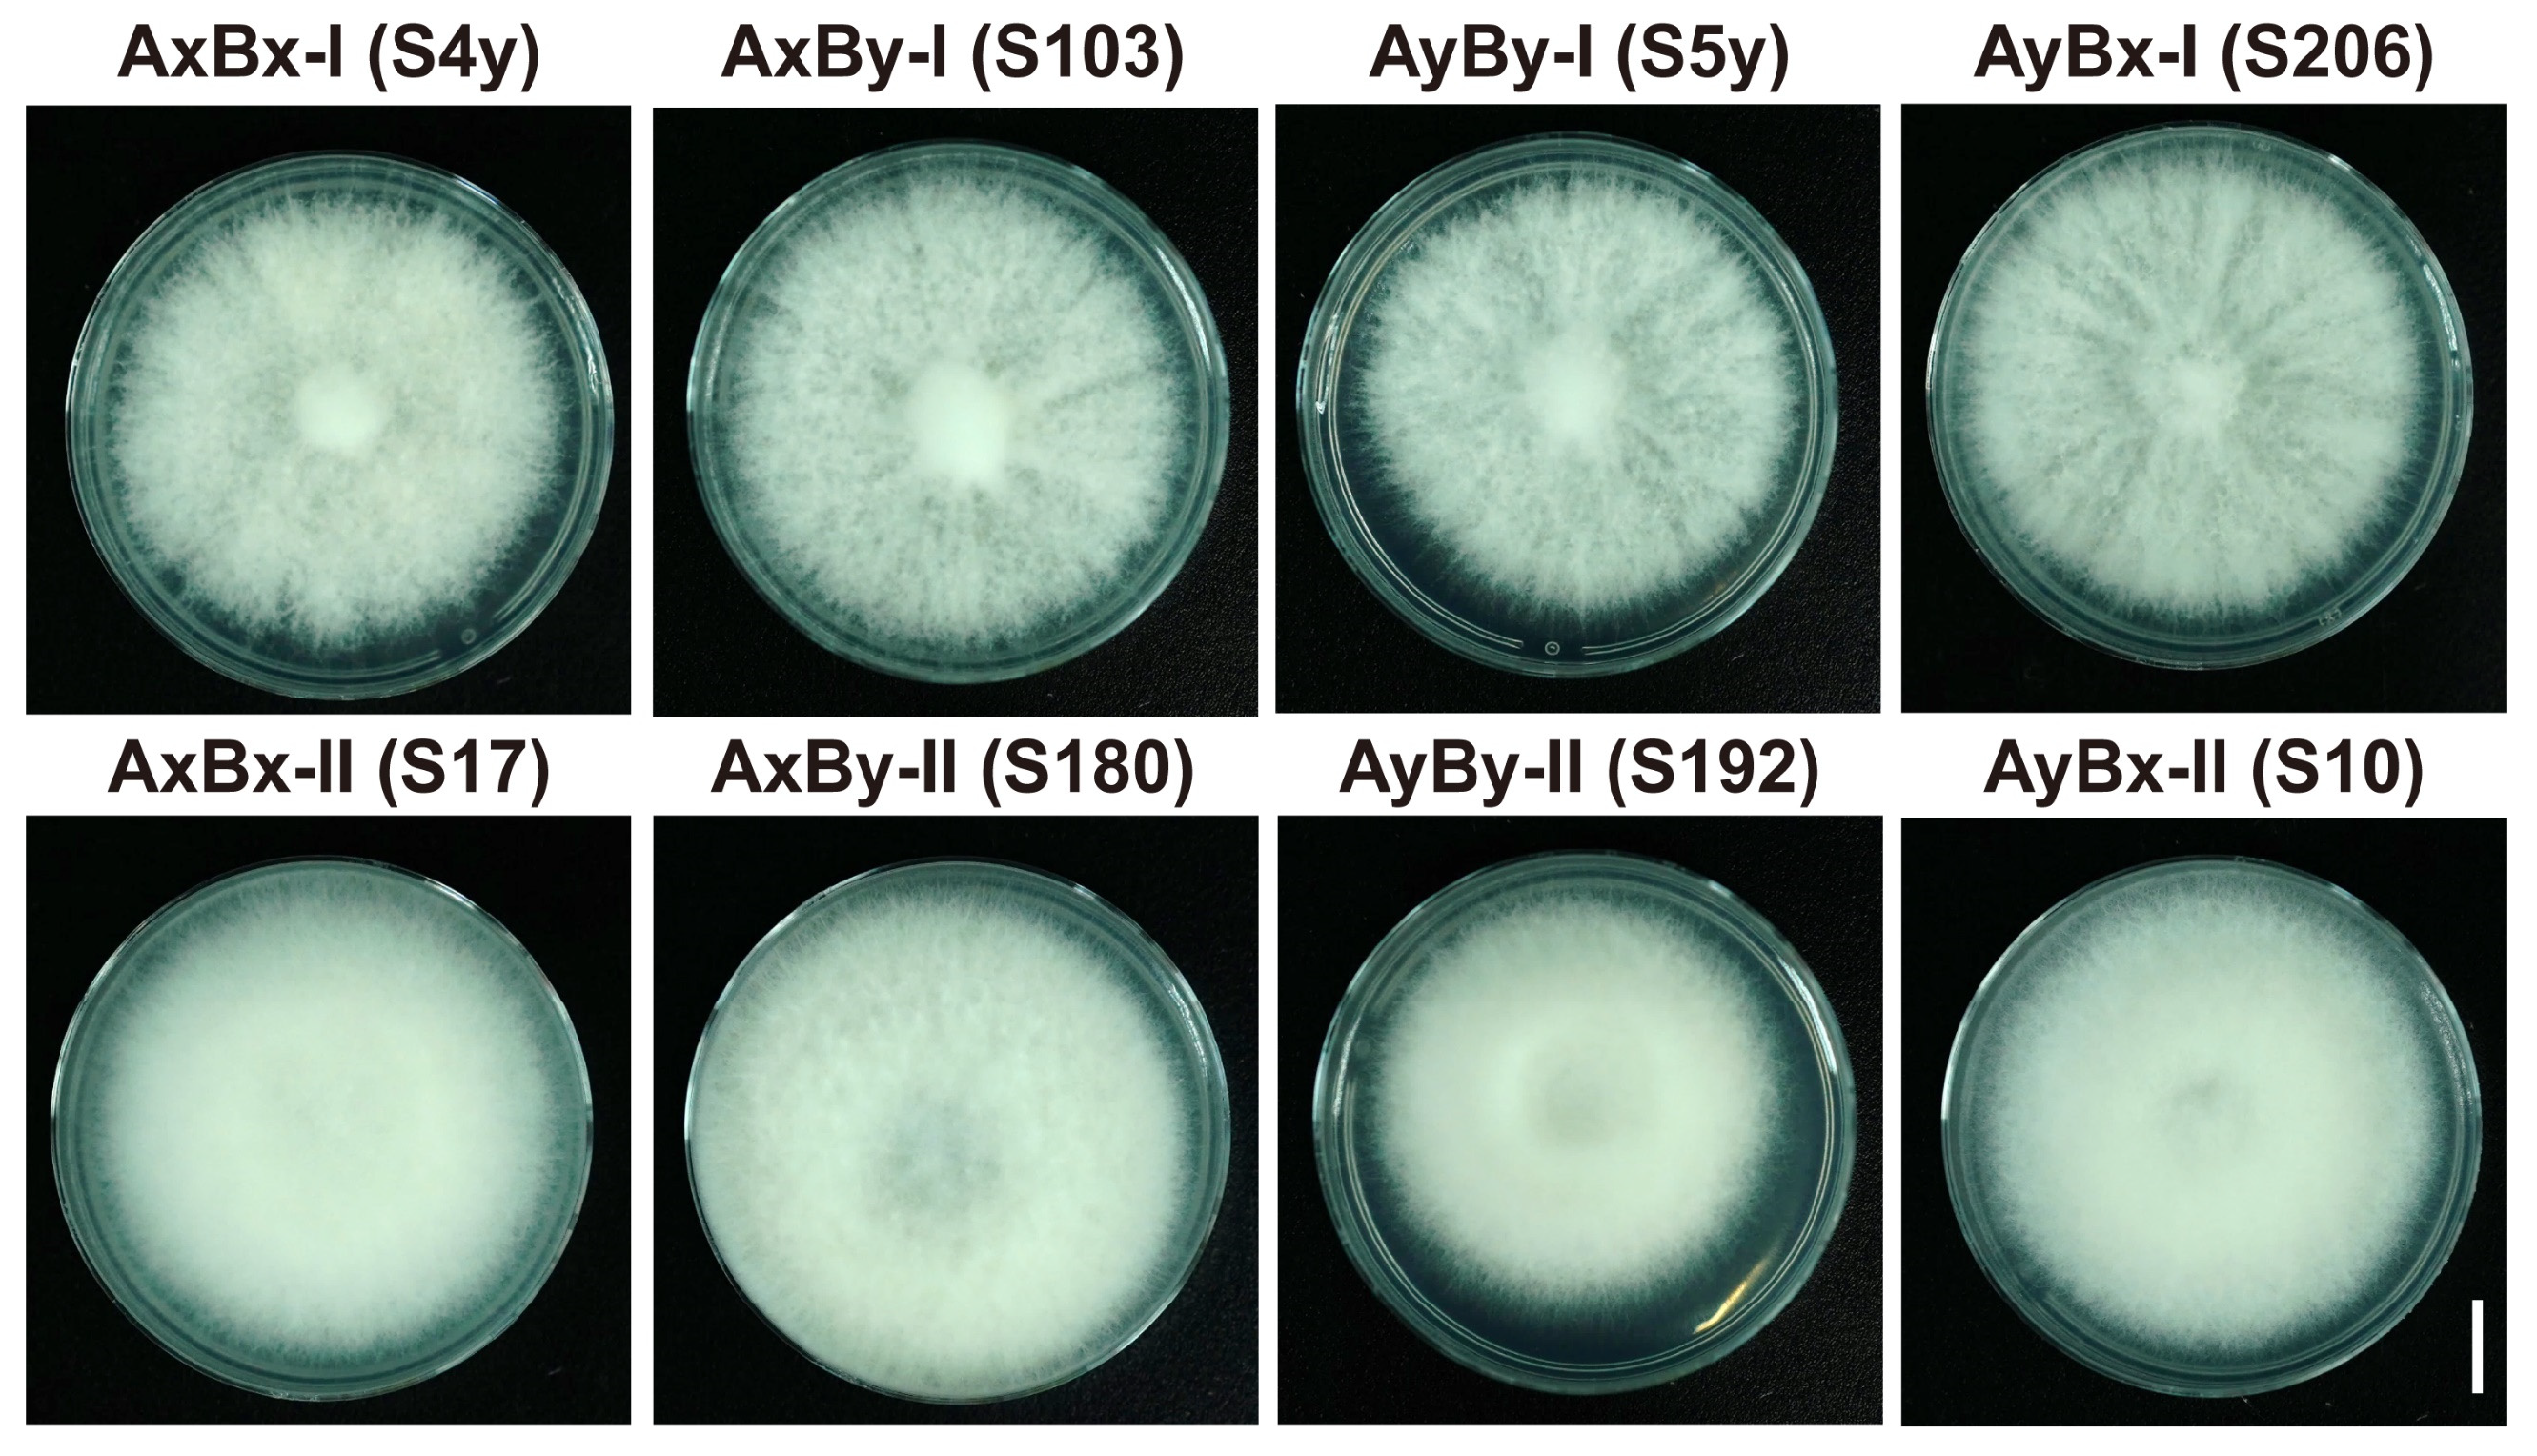
Jof 11 00277 g005

Evidence for the Existence of Mating Subtypes Within the Schizophyllum commune: Mating Behavior and Genetic Divergence
Abstract
1. Introduction
2. Materials and Methods
2.1. Fungal Strains
2.2. Obtaining Monokaryotic Strains
2.3. Mating Type Identification
2.4. Histone-Assisted Merged Fluorescence (HAMF) Assays
2.5. Gene Silencing of Pheromone-Encoding Genes bbp2-9 and bbp2-7 in S. commune
2.6. Genome Sequencing and Mating-Type Gene Annotation
3. Results
3.1. Isolation and Characterization of Mating Subtype Strains in S. commune
3.2. Observation of Hyphal Fusion and Nuclear Migration During Mating in S. commune Using Fluorescently Labeled Recombinant Strains
3.3. Identification of Putative Mating-Type Loci in S. commune and Their Role in Mating Subtype Formation
3.4. Impact of bbp2-9 and bbp2-7 Gene Silencing on Mating Subtype Formation
4. Discussion
5. Conclusions
Supplementary Materials
Author Contributions
Funding
Institutional Review Board Statement
Informed Consent Statement
Data Availability Statement
Acknowledgments
Conflicts of Interest
Abbreviations
| G1 | Colony-symmetric tetrapolar interactions |
| G2 | Colony-asymmetric tetrapolar interactions |
| HD | Homeodomain |
| Ph | Pheromone |
| PR | Pheromone receptor |
| MAT | Mating-type |
| PDA | Potato Dextrose Agar |
| MM | Minimal medium |
| HAMF | Histone-Assisted Merged Fluorescence |
| shRNA | short hairpin RNA |
| NGS | Next-generation sequencing |
| mip | mitochondrial intermediate peptidase |
| β-fg | β-flanking genes |
References
- Ohm, R.A.; De Jong, J.F.; Lugones, L.G.; Aerts, A.; Kothe, E.; Stajich, J.E.; De Vries, R.P.; Record, E.; Levasseur, A.; Baker, S.E. Genome sequence of the model mushroom Schizophyllum commune. Nat. Biotechnol. 2010, 28, 957–963. [Google Scholar] [CrossRef] [PubMed]
- Li, D.; Chu, C.; Zhao, M.; Hou, S.; Ji, R.; Liu, C. Nitric oxide-mediated regulation of chitinase activity and cadmium sequestration in the response of Schizophyllum commune to cadmium stress. Microorganisms 2025, 13, 470. [Google Scholar] [CrossRef] [PubMed]
- Mišković, J.; Karaman, M.; Rašeta, M.; Krsmanović, N.; Berežni, S.; Jakovljević, D.; Piattoni, F.; Zambonelli, A.; Gargano, M.L.; Venturella, G. Comparison of two Schizophyllum commune strains in production of acetylcholinesterase inhibitors and antioxidants from submerged cultivation. J. Fungi 2021, 7, 115. [Google Scholar] [CrossRef]
- Kumar, A.; Bharti, A.K.; Bezie, Y. Schizophyllum commune: A fungal cell-factory for production of valuable metabolites and enzymes. BioResources 2022, 17, 5420–5436. [Google Scholar] [CrossRef]
- Palmer, G.E.; Horton, J.S. Mushrooms by magic: Making connections between signal transduction and fruiting body development in the basidiomycete fungus Schizophyllum commune. FEMS Microbiol. Lett. 2006, 262, 1–8. [Google Scholar] [CrossRef] [PubMed]
- Coelho, M.A.; Bakkeren, G.; Sun, S.; Hood, M.E.; Giraud, T. Fungal sex: The Basidiomycota. Microbiol. Spectr. 2017, 5, 10–1128. [Google Scholar] [CrossRef]
- Niederpruem, D.J.; Jersild, R.A.; Lane, P.L. Direct microscopic studies of clamp connection formation in growing hyphae of Schizophyllum commune: I. The dikaryon. Arch. Mikrobiol. 1971, 78, 268–280. [Google Scholar] [CrossRef]
- L’opez, S.C.; Theelen, B.; Manserra, S.; Issak, T.Y.; Rytioja, J.; Mäkelä, M.R.; De Vries, R.P. Functional diversity in Dichomitus squalens monokaryons. IMA Fungus 2017, 8, 17–25. [Google Scholar] [CrossRef]
- Kniep, H. Uber morphologische und physiologische Geschlechtsdifferzierung. Verh. Phys.-Med. Ges. Wurzb. 1920, 46, 1–18. [Google Scholar]
- Raper, J.R.; Baxter, M.G.; Ellingboe, A.H. The genetic structure of the incompatibility factors of Schizophyllum commune: The A-factor. Proc. Natl. Acad. Sci. USA 1960, 46, 833–842. [Google Scholar] [CrossRef]
- Specht, C.A.; Stankis, M.M.; Novotny, C.P.; Ullrich, R.C. Mapping the heterogeneous DNA region that determines the nine A alpha mating-type specificities of Schizophyllum commune. Genetics 1994, 137, 709–714. [Google Scholar] [CrossRef]
- Specht, C.A.; Stankis, M.M.; Giasson, L.; Novotny, C.P.; Ullrich, R.C. Functional analysis of the homeodomain-related proteins of the A alpha locus of Schizophyllum commune. Proc. Natl. Acad. Sci. USA 1992, 89, 7174–7178. [Google Scholar] [CrossRef]
- Wendland, J.; Vaillancourt, L.; Hegner, J.; Lengeler, K.; Laddison, K.; Specht, C.; Raper, C.; Kothe, E. The mating-type locus B alpha 1 of Schizophyllum commune contains a pheromone receptor gene and putative pheromone genes. EMBO J. 1995, 14, 5271–5278. [Google Scholar] [CrossRef] [PubMed]
- Lütkenhaus, R.; Traeger, S.; Breuer, J.; Carreté, L.; Kuo, A.; Lipzen, A.; Pangilinan, J.; Dilworth, D.; Sandor, L.; Pöggeler, S. Comparative genomics and transcriptomics to analyze fruiting body development in filamentous ascomycetes. Genetics 2019, 213, 1545–1563. [Google Scholar] [CrossRef]
- Kuees, U. From two to many: Multiple mating types in Basidiomycetes. Fungal Biol. Rev. 2015, 29, 126–166. [Google Scholar] [CrossRef]
- Baranova, M.A.; Logacheva, M.D.; Penin, A.A.; Seplyarskiy, V.B.; Safonova, Y.Y.; Naumenko, S.A.; Klepikova, A.V.; Gerasimov, E.S.; Bazykin, G.A.; James, T.Y. Extraordinary genetic diversity in a wood decay mushroom. Mol. Biol. Evol. 2015, 32, 2775–2783. [Google Scholar] [CrossRef] [PubMed]
- Raper, C.A.; Raper, J.R. Mutations affecting heterokaryosis in Schizophyllum commune. Am. J. Bot. 1964, 51, 503–512. [Google Scholar] [CrossRef]
- Robertson, C.I.; Bartholomew, K.A.; Novotny, C.P.; Ullrich, R.C. Deletion of the Schizophyllum commune Aα locus: The roles of Aα Y and Z mating-type genes. Genetics 1996, 144, 1437–1444. [Google Scholar]
- Fowler, T.J.; Mitton, M.F.; Rees, E.I.; Raper, C.A. Crossing the boundary between the Bα and Bβ mating-type loci in Schizophyllum commune. Fungal Genet. Biol. 2004, 41, 89–101. [Google Scholar] [CrossRef]
- Fowler, T.J.; Mitton, M.F.; Vaillancourt, L.J.; Raper, C.A. Changes in mate recognition through alterations of pheromones and receptors in the multisexual mushroom fungus Schizophyllum commune. Genetics 2001, 158, 1491–1503. [Google Scholar] [CrossRef]
- Raper, J.R.; San Antonio, J.P. Heterokaryotic mutagenesis in Hymenomycetes. I. Heterokaryosis in Schizophyllum commune. Am. J. Bot. 1954, 41, 69–86. [Google Scholar] [CrossRef]
- Snider, P.J.; Raper, J.R. Nuclear ratios and complementation in common-A heterokaryons of Schizophyllum commune. Am. J. Bot. 1965, 52, 547–552. [Google Scholar] [CrossRef]
- Koltin, Y.; Flexer, A. Alteration of nuclear distribution in B-mutant strains of Schizophyllum commune. J. Cell Sci. 1969, 4, 739–749. [Google Scholar] [CrossRef]
- Mayfield, J.E. Septal involvement in nuclear migration in Schizophyllum commune. Arch. Microbiol. 1974, 95, 115–124. [Google Scholar] [CrossRef] [PubMed]
- Niederpruem, D.J.; Wessels, J. Cytodifferentiation and morphogenesis in Schizophyllum commune. Bacteriol. Rev. 1969, 33, 505–535. [Google Scholar] [CrossRef] [PubMed]
- Li, Y.; Yang, Y.; Huang, X.; Huang, J.; Dong, C. Molecular and genetic evidence for a tetrapolar mating system in Sparassis latifolia. Fungal Biol. 2020, 124, 1004–1012. [Google Scholar] [CrossRef]
- Kothe, E. Mating types and pheromone recognition in the homobasidiomycete Schizophyllum commune. Fungal Genet. Biol. 1999, 27, 146–152. [Google Scholar] [CrossRef]
- Inagaki, F.; Hinrichs, K.-U.; Kubo, Y.; Bowles, M.W.; Heuer, V.B.; Hong, W.-L.; Hoshino, T.; Ijiri, A.; Imachi, H.; Ito, M. Exploring deep microbial life in coal-bearing sediment down to ~2.5 km below the ocean floor. Science 2015, 349, 420–424. [Google Scholar] [CrossRef]
- Liu, C.H.; Huang, X.; Xie, T.N.; Duan, N.; Xue, Y.R.; Zhao, T.X.; Lever, M.A.; Hinrichs, K.U.; Inagaki, F. Exploration of cultivable fungal communities in deep coal-bearing sediments from ~1.3 to 2.5 km below the ocean floor. Environ. Microbiol. 2017, 19, 803–818. [Google Scholar] [CrossRef]
- Liu, X.; Huang, X.; Chu, C.; Xu, H.; Wang, L.; Xue, Y.; Muhammad, Z.U.A.; Inagaki, F.; Liu, C. Genome, genetic evolution, and environmental adaptation mechanisms of Schizophyllum commune in deep subseafloor coal-bearing sediments. iScience 2022, 25, 104417. [Google Scholar] [CrossRef]
- Jahedi, A.; Ahmadifar, S.; Mohammadigoltapeh, E. Revival of wild edible-medicinal mushroom (Hericium erinaceus) based on organic agro-industrial waste-achieving a commercial protocol with the highest yield; optimum reuse of organic waste. Sci. Hortic. 2024, 323, 112510. [Google Scholar] [CrossRef]
- Darmono, T.; Burdsall, H., Jr. Morphological characteristics of incompatibility reactions and evidence for nuclear migration in Armillaria mellea. Mycologia 1992, 84, 367–375. [Google Scholar] [CrossRef]
- Rech, C.; Engh, I.; Kück, U. Detection of hyphal fusion in filamentous fungi using differently fluorescence-labeled histones. Curr. Genet. 2007, 52, 259–266. [Google Scholar] [CrossRef]
- Van Peer, A.F.; De Bekker, C.; Vinck, A.; Wösten, H.A.; Lugones, L.G. Phleomycin increases transformation efficiency and promotes single integrations in Schizophyllum commune. Appl. Environ. Microb. 2009, 75, 1243–1247. [Google Scholar] [CrossRef]
- Inciuraite, R.; Gedgaudas, R.; Lukosevicius, R.; Tilinde, D.; Ramonaite, R.; Link, A.; Kasetiene, N.; Malakauskas, M.; Kiudelis, G.; Jonaitis, L.V. Constituents of stable commensal microbiota imply diverse colonic epithelial cell reactivity in patients with ulcerative colitis. Gut Pathog. 2024, 16, 16. [Google Scholar] [CrossRef]
- Holzberg, S.; Brosio, P.; Gross, C.; Pogue, G.P. Barley stripe mosaic virus-induced gene silencing in a monocot plant. Plant J. 2002, 30, 315–327. [Google Scholar] [CrossRef]
- Chen, S.; Zhou, Y.; Chen, Y.; Gu, J. fastp: An ultra-fast all-in-one FASTQ preprocessor. Bioinformatics 2018, 34, i884–i890. [Google Scholar] [CrossRef] [PubMed]
- Bankevich, A.; Nurk, S.; Antipov, D.; Gurevich, A.A.; Dvorkin, M.; Kulikov, A.S.; Lesin, V.M.; Nikolenko, S.I.; Pham, S.; Prjibelski, A.D. SPAdes: A new genome assembly algorithm and its applications to single-cell sequencing. J. Comput. Biol. 2012, 19, 455–477. [Google Scholar] [CrossRef]
- Waterhouse, R.M.; Seppey, M.; Simão, F.A.; Manni, M.; Ioannidis, P.; Klioutchnikov, G.; Kriventseva, E.V.; Zdobnov, E.M. BUSCO applications from quality assessments to gene prediction and phylogenomics. Mol. Biol. Evol. 2018, 35, 543–548. [Google Scholar] [CrossRef]
- Gurevich, A.; Saveliev, V.; Vyahhi, N.; Tesler, G. QUAST: Quality assessment tool for genome assemblies. Bioinformatics 2013, 29, 1072–1075. [Google Scholar] [CrossRef]
- Altschul, S.F.; Madden, T.L.; Schäffer, A.A.; Zhang, J.; Zhang, Z.; Miller, W.; Lipman, D.J. Gapped BLAST and PSI-BLAST: A new generation of protein database search programs. Nucleic Acids Res. 1997, 25, 3389–3402. [Google Scholar] [CrossRef]
- Wirth, S.; Freihorst, D.; Krause, K.; Kothe, E. What role might non-mating receptors play in Schizophyllum commune? J. Fungi 2021, 7, 399. [Google Scholar] [CrossRef] [PubMed]
- Barakate, A.; Orr, J.; Schreiber, M.; Colas, I.; Lewandowska, D.; McCallum, N.; Macaulay, M.; Morris, J.; Arrieta, M.; Hedley, P.E. Barley anther and meiocyte transcriptome dynamics in meiotic prophase I. Front. Plant Sci. 2021, 11, 619404. [Google Scholar] [CrossRef]
- Brun, S.; Kuo, H.-C.; Jeffree, C.E.; Thomson, D.D.; Read, N. Courtship ritual of male and female nuclei during fertilization in Neurospora crassa. Microbiol. Spectr. 2021, 9, e00335-21. [Google Scholar] [CrossRef] [PubMed]
- Lee, S.C.; Ni, M.; Li, W.; Shertz, C.; Heitman, J. The evolution of sex: A perspective from the fungal kingdom. Microbiol. Mol. Biol. Rev. 2010, 74, 298–340. [Google Scholar] [CrossRef]
- Pfaller, M.A.; Diekema, D. Epidemiology of invasive candidiasis: A persistent public health problem. Clin. Microbiol. Rev. 2007, 20, 133–163. [Google Scholar] [CrossRef]
- Verdú, M.; Gleiser, G. Adaptive evolution of reproductive and vegetative traits driven by breeding systems. New Phytol. 2006, 169, 409–417. [Google Scholar] [CrossRef] [PubMed]
- Raper, J.R.; Raper, C.A. Genetic regulation of sexual morphogenesis in Schizophyllum commune. J. Elisha Mitchell Sci. Soc. 1968, 84, 267–273. [Google Scholar]
- Avin, F.; Bhassu, S.; Tan, Y.; Vikineswary, S. DNA pedigree tracking to identify compatible mating partners of Pleurotus pulmonarius. JAPS J. Anim. Plant Sci. 2014, 24, 89–97. [Google Scholar]
- Raudaskoski, M. Occurrence of microtubules in the hyphae of Schizophyllum commune during intercellular nuclear migration. Arch. Mikrobiol. 1972, 86, 91–100. [Google Scholar] [CrossRef]
- Jung, E.-M.; Kothe, E.; Raudaskoski, M. The making of a mushroom: Mitosis, nuclear migration and the actin network. Fungal Genet. Biol. 2018, 111, 85–91. [Google Scholar] [CrossRef] [PubMed]
- Raudaskoski, M. The central role of septa in the basidiomycete Schizophyllum commune hyphal morphogenesis. Fungal Biol. 2019, 123, 638–649. [Google Scholar] [CrossRef] [PubMed]
- Ohm, R.A.; Aerts, D.; Wösten, H.A.; Lugones, L.G. The blue light receptor complex WC-1/2 of Schizophyllum commune is involved in mushroom formation and protection against phototoxicity. Environ. Microbiol. 2013, 15, 943–955. [Google Scholar] [CrossRef] [PubMed]
- Sen, K.; Kinoshita, H.; Tazuke, K.; Maki, Y.; Yoshiura, Y.; Yakushi, T.; Shibai, H.; Kurosawa, S.-I. Analysis of the sexual development-promoting region of Schizophyllum commune TRP1 gene. Biosci. Biotechnol. Biochem. 2016, 80, 2033–2044. [Google Scholar] [CrossRef]
- Pelkmans, J.F.; Patil, M.B.; Gehrmann, T.; Reinders, M.J.; Wösten, H.A.; Lugones, L.G. Transcription factors of Schizophyllum commune involved in mushroom formation and modulation of vegetative growth. Sci. Rep. 2017, 7, 310. [Google Scholar] [CrossRef]
- Moran, B.M.; Payne, C.Y.; Powell, D.L.; Iverson, E.N.; Donny, A.E.; Banerjee, S.M.; Langdon, Q.K.; Gunn, T.R.; Rodriguez-Soto, R.A.; Madero, A. A lethal mitonuclear incompatibility in complex I of natural hybrids. Nature 2024, 626, 119–127. [Google Scholar] [CrossRef]
- Ament-Velásquez, S.L.; Vogan, A.A.; Granger-Farbos, A.; Bastiaans, E.; Martinossi-Allibert, I.; Saupe, S.J.; de Groot, S.; Lascoux, M.; Debets, A.J.; Clavé, C. Allorecognition genes drive reproductive isolation in Podospora anserina. Nat. Ecol. Evol. 2022, 6, 910–923. [Google Scholar] [CrossRef]
- Raudaskoski, M.; Kothe, E. Basidiomycete mating type genes and pheromone signaling. Eukaryot. Cell 2010, 9, 847–859. [Google Scholar] [CrossRef]
- Knabe, N.; Jung, E.-M.; Freihorst, D.; Hennicke, F.; Horton, J.S.; Kothe, E. A central role for Ras1 in morphogenesis of the basidiomycete Schizophyllum commune. Eukaryot. Cell 2013, 12, 941–952. [Google Scholar] [CrossRef]

| Mating Reaction | Group | Colony Morphology |
|---|---|---|
| A=B= | G1 | Regular circular; no obvious boundary in the middle; edge smooth |
| G2 | Regular circular; thin hyphae on one side and dense on the other with a dividing line | |
| A≠B≠ | G1 | Irregularly radial; white and dense hyphae; margin multiple fruiting bodies |
| G2 | Irregularly but edge smooth; sparse hyphae; margin with few fruiting bodies | |
| A≠B= | G1 | Barrage reaction separates into two halves along the medium line; white and aerial hyphae |
| G2 | Barrage reaction with semi-arc fence structure; white and aerial hyphae | |
| A=B≠ | G1 | Flat reaction separates in half along the medium line; translucent hyphae |
| G2 | Flat reaction with semi-arc fence structure; translucent hyphae |
| Mating Subtypes | Strains | S4y | S17 | S103 | S180 | S5y | S192 | S206 | S10 | |
|---|---|---|---|---|---|---|---|---|---|---|
| AxBx | I | S4y | A=B= G1 | |||||||
| II | S17 | A=B= G2 | A=B= G1 | |||||||
| AxBy | I | S103 | A=B≠ G1 | A=B≠ G2 | A=B= G1 | |||||
| II | S180 | A=B≠ G2 | A=B≠ G1 | A=B= G2 | A=B= G1 | |||||
| AyBy | I | S5y | A≠B≠ G1 | A≠B≠ G2 | A≠B= G1 | A≠B= G2 | A=B= G1 | |||
| II | S192 | A≠B≠ G2 | A≠B≠ G1 | A≠B= G2 | A≠B= G1 | A=B= G2 | A=B= G1 | |||
| AyBx | I | S206 | A≠B= G1 | A≠B= G2 | A≠B≠ G1 | A≠B≠ G2 | A=B≠ G1 | A=B≠ G2 | A=B= G1 | |
| II | S10 | A≠B= G2 | A≠B= G1 | A≠B≠ G2 | A≠B≠ G1 | A=B≠ G2 | A=B≠ G1 | A=B= G2 | A=B= G1 | |
| Mating Reaction | Group | Hyphal Fusion | Nuclear Migration | Nuclear Fusion | Clamp Connection |
|---|---|---|---|---|---|
| A=B= | G1 | − | − | − | − |
| G2 | |||||
| A≠B≠ | G1 | + | + | + | + |
| G2 | |||||
| A=B≠ | G1 | + | + | − | − |
| G2 | |||||
| A≠B= | G1 | + | − | − | − |
| G2 |
Disclaimer/Publisher’s Note: The statements, opinions and data contained in all publications are solely those of the individual author(s) and contributor(s) and not of MDPI and/or the editor(s). MDPI and/or the editor(s) disclaim responsibility for any injury to people or property resulting from any ideas, methods, instructions or products referred to in the content. |
© 2025 by the authors. Licensee MDPI, Basel, Switzerland. This article is an open access article distributed under the terms and conditions of the Creative Commons Attribution (CC BY) license (https://creativecommons.org/licenses/by/4.0/).
Share and Cite
Chu, C.; Li, D.; Gu, L.; Yang, S.; Liu, C. Evidence for the Existence of Mating Subtypes Within the Schizophyllum commune: Mating Behavior and Genetic Divergence. J. Fungi 2025, 11, 277. https://doi.org/10.3390/jof11040277
Chu C, Li D, Gu L, Yang S, Liu C. Evidence for the Existence of Mating Subtypes Within the Schizophyllum commune: Mating Behavior and Genetic Divergence. Journal of Fungi. 2025; 11(4):277. https://doi.org/10.3390/jof11040277
Chicago/Turabian StyleChu, Chen, Dongxu Li, Linqing Gu, Sihai Yang, and Changhong Liu. 2025. "Evidence for the Existence of Mating Subtypes Within the Schizophyllum commune: Mating Behavior and Genetic Divergence" Journal of Fungi 11, no. 4: 277. https://doi.org/10.3390/jof11040277
APA StyleChu, C., Li, D., Gu, L., Yang, S., & Liu, C. (2025). Evidence for the Existence of Mating Subtypes Within the Schizophyllum commune: Mating Behavior and Genetic Divergence. Journal of Fungi, 11(4), 277. https://doi.org/10.3390/jof11040277

